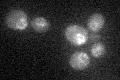
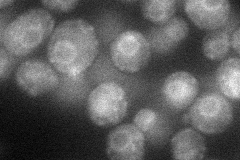
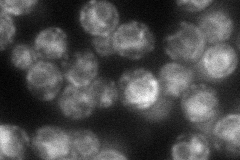
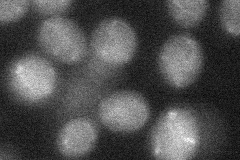
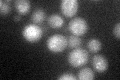

View description
Essential nuclear envelope integral membrane protein required for nuclear envelope morphology, nuclear pore complex localization, nuclear export; exhibits synthetic lethal genetic interactions with genes involved in lipid metabolism
Localization:
Intensity:
Fold change:
Significance:
-
C’ GFP library in SD
nuclear periphery22.58 -
N' NOP1pr-GFP in SD
cell periphery,ER,punctate33.8995 -
N' TEF2pr-mCherry in SD
ER,vacuole50.2872 -
N' NATIVEpr-GFP in SD

below threshold15.7625 -
N' TEF2pr-VC and Cyto-VN in SD
below threshold25.1555 -
C’ GFP library in SD+DTT
nuclear periphery17.660.78Yes -
C’ GFP library in SD+H2O2

nuclear periphery18.180.8Yes -
C’ GFP library in Starvation Media

nuclear periphery180.79Yes -
C’ GFP library on the background of Pup2-DaMP

nuclear periphery -
C’ GFP library on the background of CCT mutant

nuclear periphery21.53070.953479No
